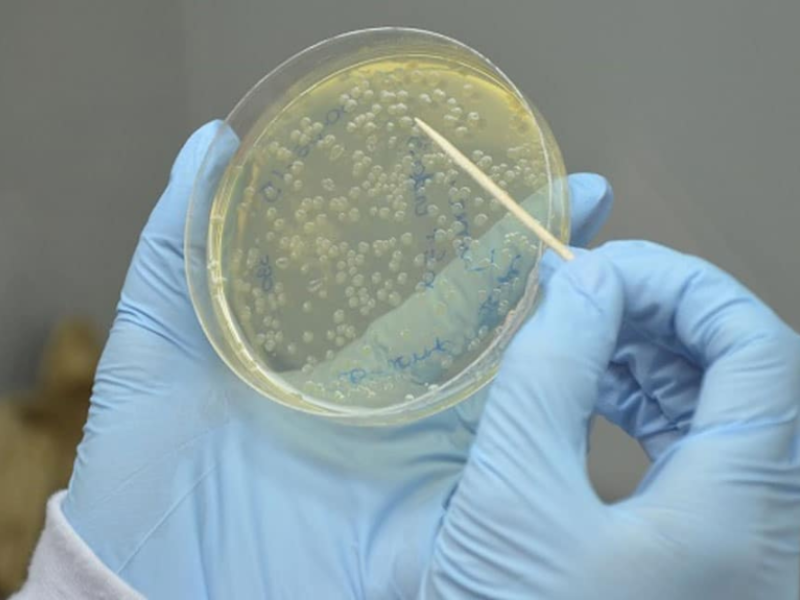
Design Sem Nome 11

Perovskite Solar Cells Keep 90% of Their Efficiency at 90°C Thanks To Ionic Liquids
Solar cells, which produce electricity from sunlight, are already contributing to lower fossil fuel emissions in numerous countries around the world. Recently, energy engineers have been exploring alternatives to silicon to create solar cells that are more efficient, long-lasting, and cost-effective. These materials include perovskites, especially halide perovskites, which have a distinctive ABX₃ crystal structure […]
Perovskite Solar Cells Keep 90% of Their Efficiency at 90°C Thanks To Ionic Liquids Read More »